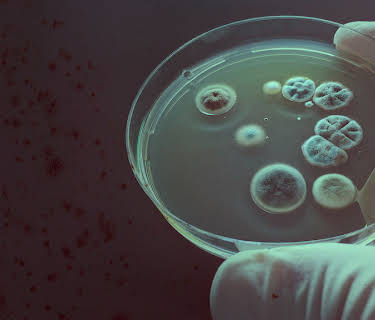
Mystiske sykdommer

Serie fra 2018
| Varighed: | 42 min |
|---|---|
| Genre: | Drama, Børn, Action |
Forbløffende symptomer, kontroversielle diagnoser og dyre behandlinger. Syv mennesker med kroniske sykdommer leter etter svar – og lindring.
Trådløse nettverk og elektrisitet utløser Carmens merkelige symptomer. Jamison har ikke vært ute på to år. Bekah bor i en van i ørkenen for å unngå mugg.
Star har fått et dusin ulike diagnoser. Broren til Bekah kommer for å ta seg av henne. Familien til Jamison leter etter en spesialist.
Den unge musikeren Jake sliter med symptomer på Lymes sykdom. Star blir behandlet for dystoni. Carmen besøker en by der det ikke finnes mobiltelefoner.
Pilar, en skuespiller med overfølsomhet for kjemikalier, bor ikke sammen med mannen sin. Jake og Bekah møter skeptiske leger når de trenger akutt helsehjelp.
Terapeuten Jill tar opptil 55 ulike kosttilskudd daglig. Stars behandling koster 11 000 dollar for to uker. Ektemannen til Pilar tar seg ekstrajobb for å dekke utgiftene.
En healer behandler Pilar over telefonen. Jake og kjæresten hans kjører 10 timer for å komme til en klinikk. En venn av Jill er redd for at legene utnytter henne.
Jill vurderer en behandling som koster 30 000 dollar. Bekah får et nytt spesialtilpasset hjem. Pilar, Star og Carmen blir bedre, og Jamison og Jake passerer milepæler.